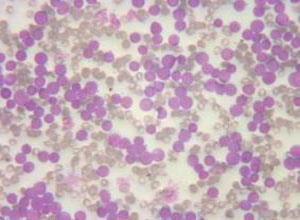
小儿非内脂性网状内皮增殖综合征

医疗知识
基本知识
- 是否医保:否
- 易感人群:儿童
- 患病比例:0.03%(有遗传病史的小儿人群,发病率较高)
- 传染方式:无传染性
- 并发症:中耳炎、 肺纤维化
治疗常识
- 挂号科室:儿科 儿科综合
- 治疗方式:药物治疗 支持治疗
- 治疗周期:2-4月
- 治愈率:45%
- 常用药品:头孢氨苄胶囊、盐酸左氧氟沙星胶囊
治疗费用:根据不同医院,收费标准不一致,市三甲医院约(1000——5000元)
温馨提示:本病征经多种治疗预后已大为改善,但起病年龄越小,受侵器官越多,病程进展快且严重,预后越差,有内脏损害和神经系统损害者预示着暴发性的经过,病死率约50%,多在发病后2~3年内死亡。
饮食保健
小儿非内脂性网状内皮增殖综合征宜吃食材
小儿非内脂性网状内皮增殖综合征忌吃食材